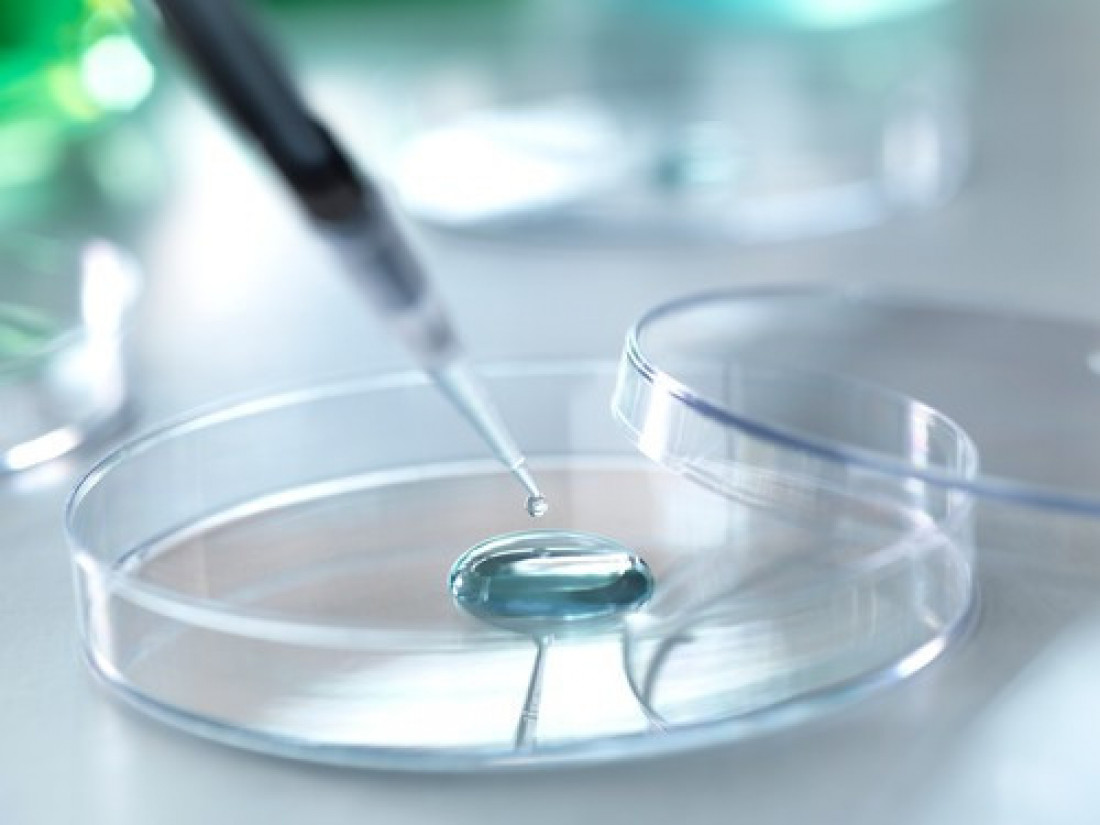

Za više od dve godine neonatalnog skrininga, SMA dijagnostikovana kod 20 beba u Srbiji
Komentari
Spinalna mišićna atrofija (SMA), danas se u Srbiji otkriva već na rođenju, a od uvođenja obaveznog neonatalnog skrininga u septembru 2023. godine testirano je 136.899 beba, a kod 20 je potvrđena dijagnoza SMA.
U Srbiji je ovo omogućilo pravovremeno započinjanje terapije i značajno bolje ishode lečenja donedavno najsmrtonosnije genetske bolesti dece do pete godine, saopštilo je Udruženje SMA Srbija.
Neuropedijatar Univerzitetske dečje klinike u Tiršovoj Dimitrije Nikolić objasnio je da je reč o bolesti kod koje je vreme presudno, jer se sa svakim danom bez terapije gube motorni neuroni i smanjuje mogućnost postizanja boljih funkcionalnih ishoda.
"Upravo zato je uvođenje obaveznog neonatalnog skrininga predstavljalo ključnu prekretnicu u lečenju ove bolesti u Srbiji, jer nam je omogućilo da pacijente prepoznamo u najranijoj fazi, pre pojave simptoma. U skladu sa važećim stručnim preporukama, najveći broj dijagnostikovanih pacijenata je pravovremeno započeo odgovarajuću terapiju", objasnio je Nikolić.
Dodao je da terapija nije uvedena kod dva pacijenta kod kojih je utvrđeno prisustvo pet kopija SMN2 gena, jer za ovu grupu trenutno ne postoje jasne preporuke za započinjanje lečenja.
"Ova deca se nalaze pod posebnim i kontinuiranim stručnim praćenjem, uz redovne kontrole i pažljivu procenu potrebe za eventualnim terapijskim intervencijama. Posebno želim da istaknem da smo tokom 2025. godine uspeli da značajno skratimo administrativne procedure i da vreme od postavljanja dijagnoze do odobravanja terapije svedemo na svega nekoliko dana. Od trenutka potvrde dijagnoze u molekularno-genetskoj laboratoriji, pa do odobravanja terapije, ceo proces danas funkcioniše brzo i efikasno, što omogućava da pacijenti praktično odmah započnu lečenje", istakao je Nikolić.
Kako je naveo, pored same terapije, veliki akcenat se stavlja i na dugoročno, multidisciplinarno praćenje pacijenata, koje uključuje individualizovanu rehabilitaciju, adekvatnu nutritivnu i respiratornu podršku, kao i preventivne mere, kako bi se deci sa SMA omogućio najbolji mogući kvalitet života i ostvarivanje njihovog punog razvojnog potencijala.
SMA je retka, ozbiljna, progresivna bolest, čiji simptomi mogu da se razviju već u prvim mesecima života.
Svaka 35-37. osoba u opštoj populaciji je nosilac resecivnog gena za SMA.
Kad se dve takve osobe sretnu i reše da prave potomstvo postoji 25 odsto šanse da se rodi dete koje je obolelo od SMA.
Jedini način da stručnjaci pronađu takvu genetsku mutaciju na vreme je skrining tek rođene dece koji dijagnostikuje bolest u predsimptomatskoj fazi, koji je u našoj zemlji zakonski postao obavezan od 14. septembra 2023. godine.
Udruženje SMA Srbija osnovano je pre devet godina i tada se malo znalo o ovoj bolesti.
profimedia
Na srpskom jeziku se na internetu nije moglo naći gotovo ništa o SMA.
Sama dijagnostika je bila mnogo lošija, dok je danas situacija potpuno drugačija i to mnogo govori o radu Udruženja.
"Terapija menja život"
Prvi pacijenti počeli su da se leče tek 2018. godine, a terapija je tada bila odobrena za samo četiri pacijenta.
Potpredsednica Udruženja SMA Srbija Aleksandra Martinović naglasila je da kao majka deteta sa SMA i potpredsednica Udruženja, zna iz ličnog iskustva da terapija menja život, ali da sama po sebi nije dovoljna.
"Moja ćerka je terapiju započela sa četiri godine, nakon ozbiljnih zdravstvenih komplikacija, i iako je terapija donela stabilizaciju bolesti, izazovi i dalje postoje. Zato je pored lekova neophodna kontinuirana, multidisciplinarna zdravstvena podrška, rehabilitacija, kao i sistemska briga koja obezbeđuje kvalitetan i dostojanstven život", rekla je Martinović.
Kako je istakla, posebno je važno da u fokusu ostanu i odrasli pacijenti sa SMA, jer terapija ne sme biti pitanje uzrasta, već osnovno pravo svakog pacijenta.
"Danas mnogi adultni pacijenti zahvaljujući terapiji imaju priliku za stabilizaciju bolesti, očuvanje funkcionalnosti i veću samostalnost, ali još uvek postoje oni koji čekaju i zbog kojih nemamo pravo da stanemo. Naša borba ne završava se u zdravstvenom sistemu", objasnila je Martinović.
Ona je dodala da prava inkluzija znači dostupno obrazovanje, prilagođeno radno okruženje, arhitektonsku pristupačnost i mogućnost aktivnog učešća u društvu.
"Lečenje bez inkluzije znači preživljavanje, ali lečenje uz inkluziju znači život. Udruženje SMA Srbija ostaje posvećeno tome da nijedan pacijent ne ostane bez terapije, podrške i prilike za dostojanstven život", rekla je Martinović.























Komentari (0)